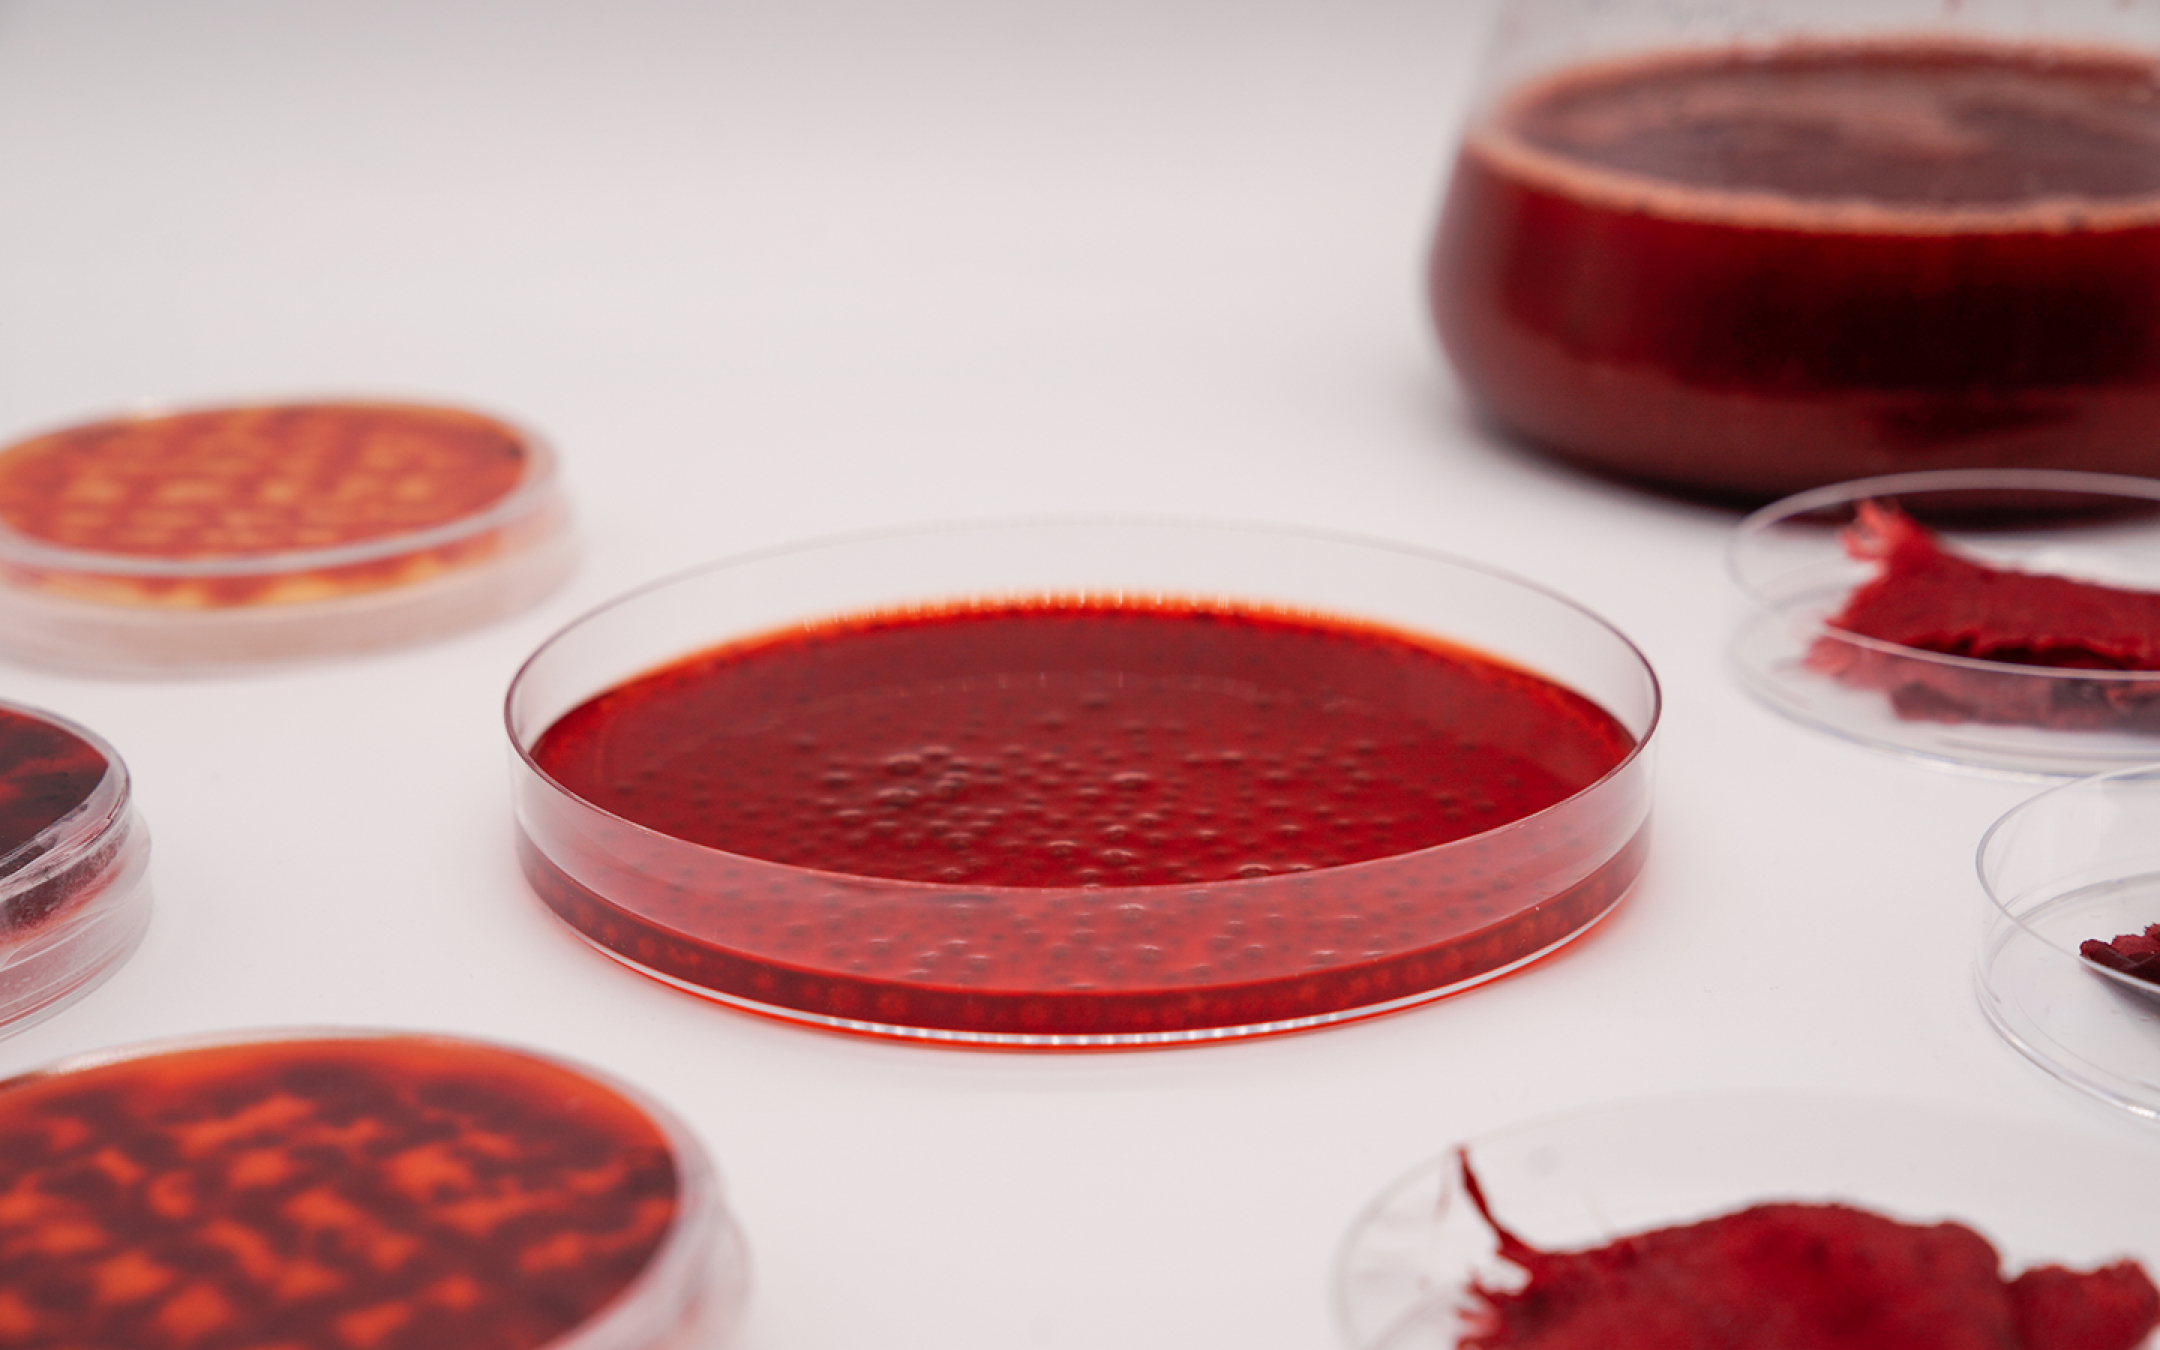
MycoColors

MycoColors Germany
We believe in a fungi based future of colors
Colors are everywhere - almost no industrial product succeed without them. But the process of dyeing causes one of the biggest environmental problems on our planet. Most synthetic dyes are toxic, carcinogenic and harmful to the ecosystem. Fungi offer a broad spectrum of natural colors. MycoColors is exploring the potential of fungal based dyes. Primary goals are the development of sustainable extraction and dyeing processes to establish alternative colorants for textiles. Interdisciplinary thinking in the combination of biotech, design and nature is the innovative power of MycoColors.
Company/Institution: TU Berlin, KH Berlin